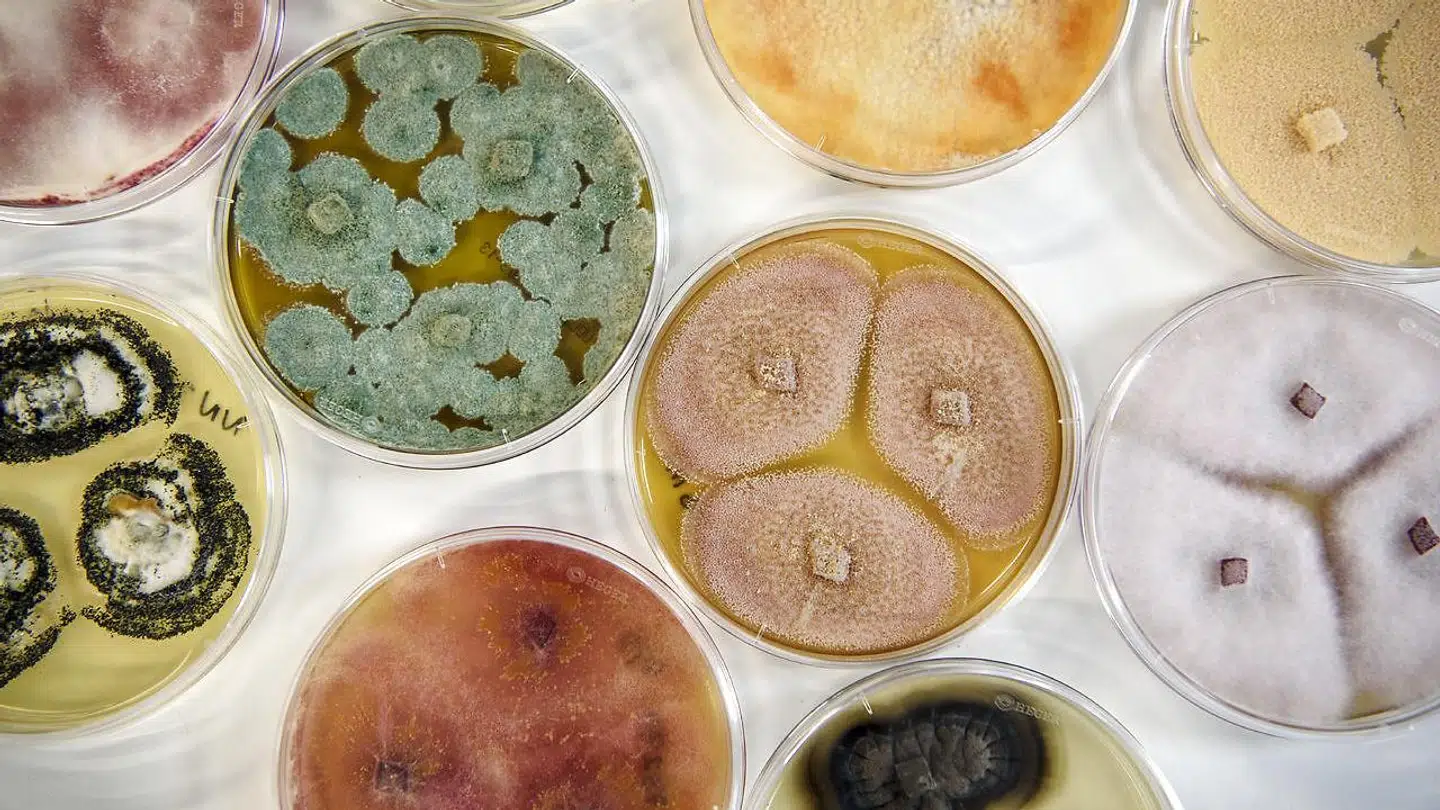

Potentialet i en fusion imellem Novozymes og Chr. Hansen er ikke indregnet i aktiekurserne.
Det vurderer Jakob Westh Christensen, der er nordisk markedsanalytiker hos handelsplatformen eToro i en kommentar om de to C25-selskaber, der i uventet træk er på vej til at gå sammen.
Fortsæt uden at betale en krone
Få adgang til artiklen, vores nyhedsbreve og mange flere login-fordele.
Se mereDel: